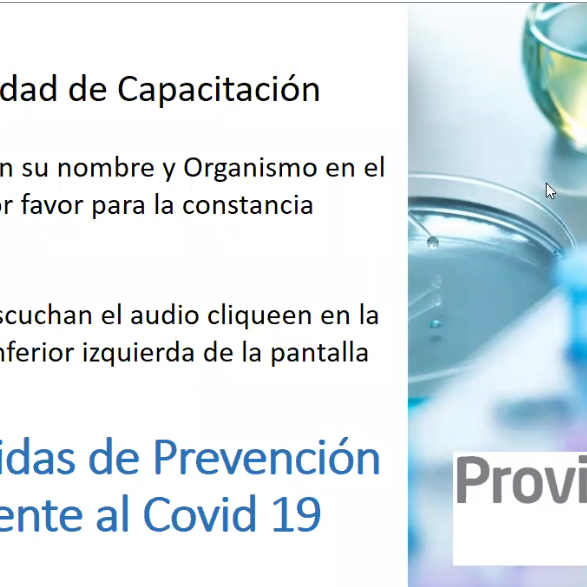

[/vc_column_text][/vc_column][/vc_row]
PROGRAMA PREVEN COVID-19. Abril 2020
PROGRAMA COVID-19. Abril 2020
En el mes de Abril, lanzamos el programa “Preven Covid-19”, a través del cual brindamos asesoramiento para la prevención, contención y mitigación del Covid-19….
CAPACITACIONES- PLATAFORMA ZOOM. Abril 2020
CAPACITACIONES - PLATAFORMA ZOOM. Abril 2020
Durante el mes de abril, incorporamos jornadas de capacitación para la Prevención del Covid-19, dictadas por…
CAPACITACIONES ZOOM MAYO 2020 - COVID + DENGUE